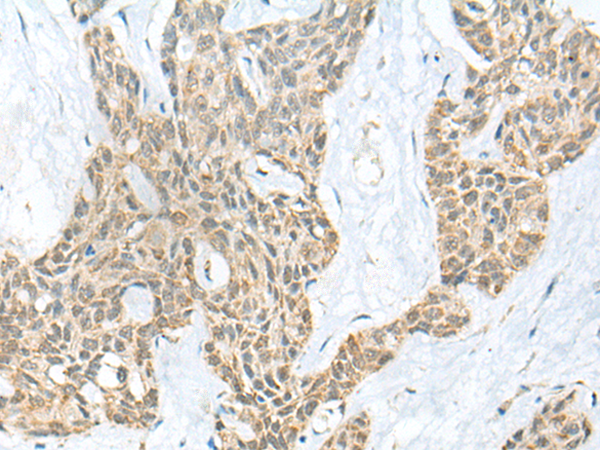

中文名稱:兔抗YY1多克隆抗體
|
Background: |
YY1 is a ubiquitously distributed transcription factor belonging to the GLI-Kruppel class of zinc finger proteins. The protein is involved in repressing and activating a diverse number of promoters. YY1 may direct histone deacetylases and histone acetyltransferases to a promoter in order to activate or repress the promoter, thus implicating histone modification in the function of YY1. |
|
Applications: |
ELISA, IHC |
|
Name of antibody: |
YY1 |
|
Immunogen: |
Synthetic peptide of human YY1 |
|
Full name: |
YY1 transcription factor |
|
Synonyms: |
DELTA; NF-E1; UCRBP; INO80S; YIN-YANG-1 |
|
SwissProt: |
P25490 |
|
ELISA Recommended dilution: |
5000-10000 |
|
IHC positive control: |
Human esophagus cancer |
|
IHC Recommend dilution: |
25-100 |
購物車
購物車 幫助
幫助
 021-54845833/15800441009
021-54845833/15800441009
